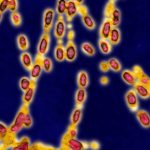
UCLA develops nanoparticle system to treat bioterrorism organism UCLA develops nanoparticle system to treat bioterrorism organism

Study proves all humans have a little microorganism DNA
Alastair Crisp from the University of Cambridge and colleagues are the first to show that most mammals including humans have incorporated some DNA from...
‘Cord milking’ boosts blood flow to preemies
A new technique used to increase the flow of blood from the umbilical cord to the circulatory system of premature infants delivered by cesarean...
Study: Skin cell damage occurs even after you’ve taken cover from UV rays
Maybe stepping away from the sun after you’ve been exposed to too much of its rays used to be a way to avoid damage...
UCLA develops nanoparticle system to treat bioterrorism organism
Tularemia is a serious infectious disease caused by the bacterium Francisella tularensis. The disease is named after Tulare County, California. The Centers for Disease...
Australian researchers discover new neurodevelopmental disorder
Australian researchers have discovered a new neurodevelopmental disorder after uncovering its link to a tumor suppressor gene.
The international research collaboration, led by the Murdoch...
Mindfulness intervention enhances brain activation for healthy pleasures
There has been a growing interest in the value of mindfulness intervention to help improve the well being of people. The University of Utah...
Many women with menopausal systems are untreated
Hot flashes and other menopausal symptoms may significantly affect a women’s quality of life. However, according to a new study, many menopausal women do...
Intestinal bacteria provide clues to aging
Most of us strive for a long—and healthy life. However, some individuals maintain excellent health in their 80s and beyond while others develop significant...
Panel recommends HPV test replace Pap test for cervical cancer screening
For decades, the Pap test has been the standard testing method for testing for cancer of the cervix. More recently, the human papillomavirus (HPV)...
Study: Five minute breathing exercises found to boost tolerance for the treadmill
Despite the myriad known benefits of exercise, many middle-aged and older adults struggle to meet physical activity recommendations. New research finds potential for high-resistance...
Top News
Hey ISIS, You Suck: Local Muslims Post Anti-ISIS Billboard
A new billboard on Manchester Road in Missouri reads, "HEY ISIS, YOU SUCK!!! From: #ActualMuslims."
A group of Muslim-Americans have put up a blunt billboard...